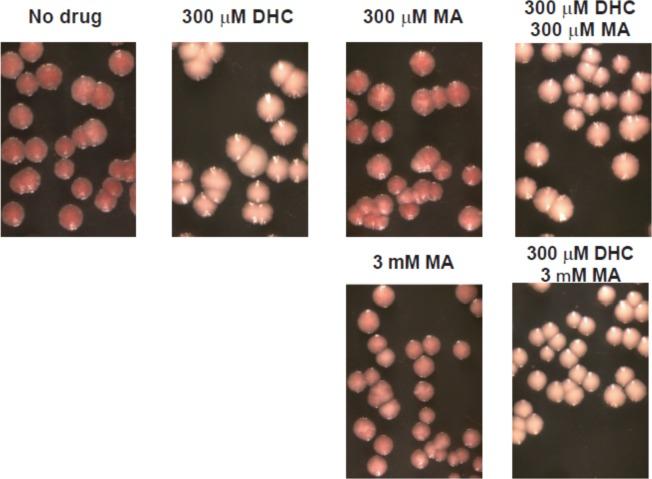
https://cdn.ncbi.nlm.nih.gov/pmc/blobs/0740/4755582/3a40b05533af/pone.0149207.g011.jpg

膳食生物活性化合物二氢香豆素对沉默调节蛋白功能和生物利用度的影响。
Impacts on Sirtuin Function and Bioavailability of the Dietary Bioactive Compound Dihydrocoumarin.
作者信息
Jacobi Jennifer L, Yang Bo, Li Xu, Menze Anna K, Laurentz Sara M, Janle Elsa M, Ferruzzi Mario G, McCabe George P, Chapple Clint, Kirchmaier Ann L
机构信息
Department of Biochemistry, Purdue University, West Lafayette, Indiana, United States of America.
Purdue Center for Cancer Research, Purdue University, West Lafayette, Indiana, United States of America.
出版信息
PLoS One. 2016 Feb 16;11(2):e0149207. doi: 10.1371/journal.pone.0149207. eCollection 2016.
The plant secondary metabolite and common food additive dihydrocoumarin (DHC) is an inhibitor of the Sirtuin family of NAD+-dependent deacetylases. Sirtuins are key regulators of epigenetic processes that maintain silent chromatin in yeast and have been linked to gene expression, metabolism, apoptosis, tumorogenesis and age-related processes in multiple organisms, including humans. Here we report that exposure to the polyphenol DHC led to defects in several Sirtuin-regulated processes in budding yeast including the establishment and maintenance of Sir2p-dependent silencing by causing disassembly of silent chromatin, Hst1p-dependent repression of meiotic-specific genes during the mitotic cell cycle. As both transient and prolonged exposure to environmental and dietary factors have the potential to lead to heritable alterations in epigenetic states and to modulate additional Sirtuin-dependent phenotypes, we examined the bioavailability and digestive stability of DHC using an in vivo rat model and in vitro digestive simulator. Our analyses revealed that DHC was unstable during digestion and could be converted to melilotic acid (MA), which also caused epigenetic defects, albeit less efficiently. Upon ingestion, DHC was observed primarily in intestinal tissues, but did not accumulate over time and was readily cleared from the animals. MA displayed a wider tissue distribution and, in contrast to DHC, was also detected in the blood plasma, interstitial fluid, and urine, implying that the conversion of DHC to the less bioactive compound, MA, occurred efficiently in vivo.
植物次生代谢产物及常见食品添加剂二氢香豆素(DHC)是烟酰胺腺嘌呤二核苷酸(NAD⁺)依赖性去乙酰化酶Sirtuin家族的抑制剂。Sirtuins是表观遗传过程的关键调节因子,可在酵母中维持染色质沉默,并且与包括人类在内的多种生物体的基因表达、代谢、细胞凋亡、肿瘤发生及衰老相关过程有关。在此,我们报告称,暴露于多酚类物质DHC会导致出芽酵母中几个受Sirtuin调节的过程出现缺陷,包括通过引起沉默染色质的解体来建立和维持Sir2p依赖性沉默,以及在有丝分裂细胞周期中Hst1p依赖性抑制减数分裂特异性基因。由于短期和长期暴露于环境及饮食因素都有可能导致表观遗传状态的可遗传改变,并调节其他Sirtuin依赖性表型,因此我们使用体内大鼠模型和体外消化模拟器研究了DHC的生物利用度和消化稳定性。我们的分析表明,DHC在消化过程中不稳定,可转化为草木犀酸(MA),后者也会导致表观遗传缺陷,尽管效率较低。摄入后,主要在肠道组织中观察到DHC,但它不会随时间积累,并且很容易从动物体内清除。MA表现出更广泛的组织分布,与DHC不同的是,在血浆、组织间液和尿液中也检测到了MA,这意味着DHC在体内有效地转化为生物活性较低的化合物MA。